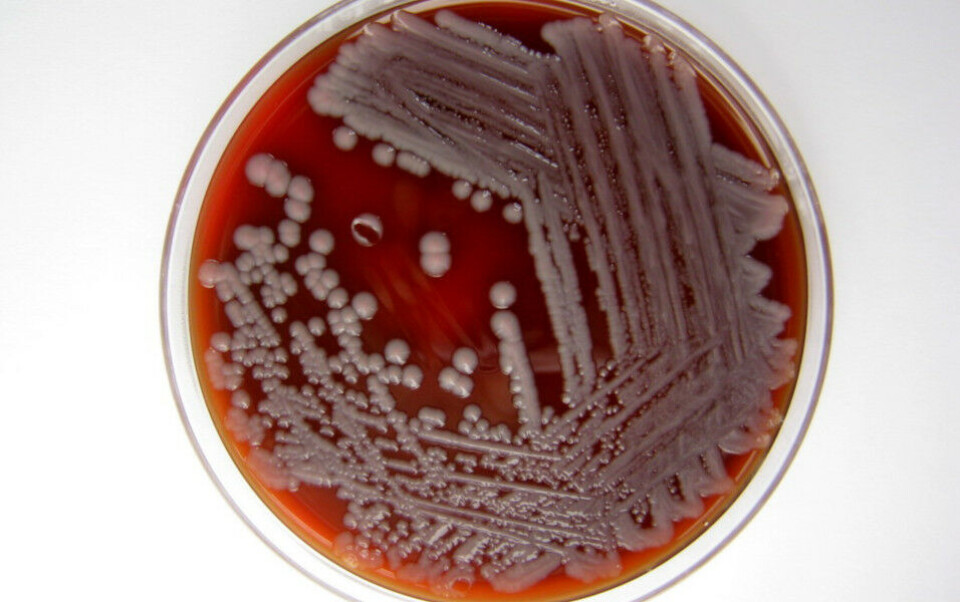

Aktuelt
Utbrudd med Serratia marcescens ved flere sykehus
Per 9. november er det meldt om til sammen 17 tilfeller fra to av landets fire helseregioner.
Utbruddet ble oppdaget i oktober, da sykehus i Helse Midt-Norge reagerte på en økning i antall pasienter i regionen som fikk påvist Serratia marcescens. Sju av disse tilfellene viste seg å være identiske bakteriestammer med samme genetiske profil, skriver Folkehelseinstituttet på sine nettsider.
Helse Midt-Norge undersøkte da også tidligere pasientprøver, og har til sammen identifisert ni tilfeller med samme bakteriestamme fra 2022 og ett fra 2021.
Sykehus i Helse Sør-Øst har funnet bakteriestammen i til sammen sju pasientprøver. Det er meldt om tre dødsfall der infeksjonen kan ha vært en medvirkende årsak.
– FHI bidrar nå i utbruddsarbeidet ved å koordinere en gruppe med representanter fra alle helseregioner, sier overlege Arne Taxt i Folkehelseinstituttet.
I tillegg er Mattilsynet og Statens legemiddelverk med i etterforskningen.
Så langt er smittekilden ikke funnet.
Folkehelseinstituttet skriver at Serratia marcescens er en vanlig forekommende bakterie, som blant annet trives i vann og fuktige omgivelser, samt i sykehusmiljø. Den forårsaker sjelden sykdom hos friske, men kan gi alvorlig sykdom hos pasienter med svekket immunforsvar. Infeksjoner med Serratia marcescens kan behandles med antibiotika.
PS!
Vinteren 2021/22 rammet et pseudomonasutbrudd over 300 pasienter på norske sykehus. Her er historien om hvordan utbruddet ble etterforsket og oppklart:
























